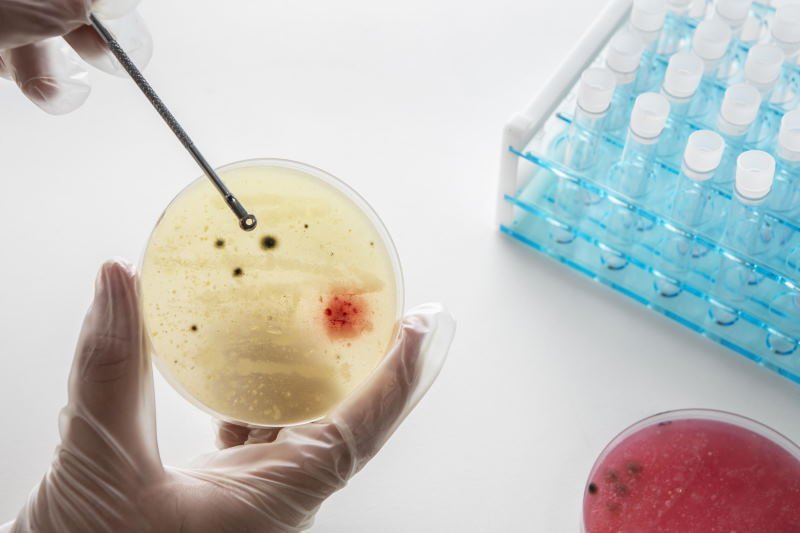
Цитологическое исследование пунктатов молочной железы - ранняя диагностика рака груди

Медицинские анализы
Анализы на гормоны
Featured

Норма дегидроэпиандростерон-сульфата (ДГЭА-SO4) и причины отклонений
Анализы на инфекции
Featured
Анализы на онкомаркеры
Featured
Биохимические анализы крови
Featured
Пищевые аллергены
Featured
Анализы на цитологию
Featured
* Цены указана без учета стоимости взятия биоматериала. При единовременном заказе нескольких услуг, услуга по сбору биоматериала оплачивается только один раз.